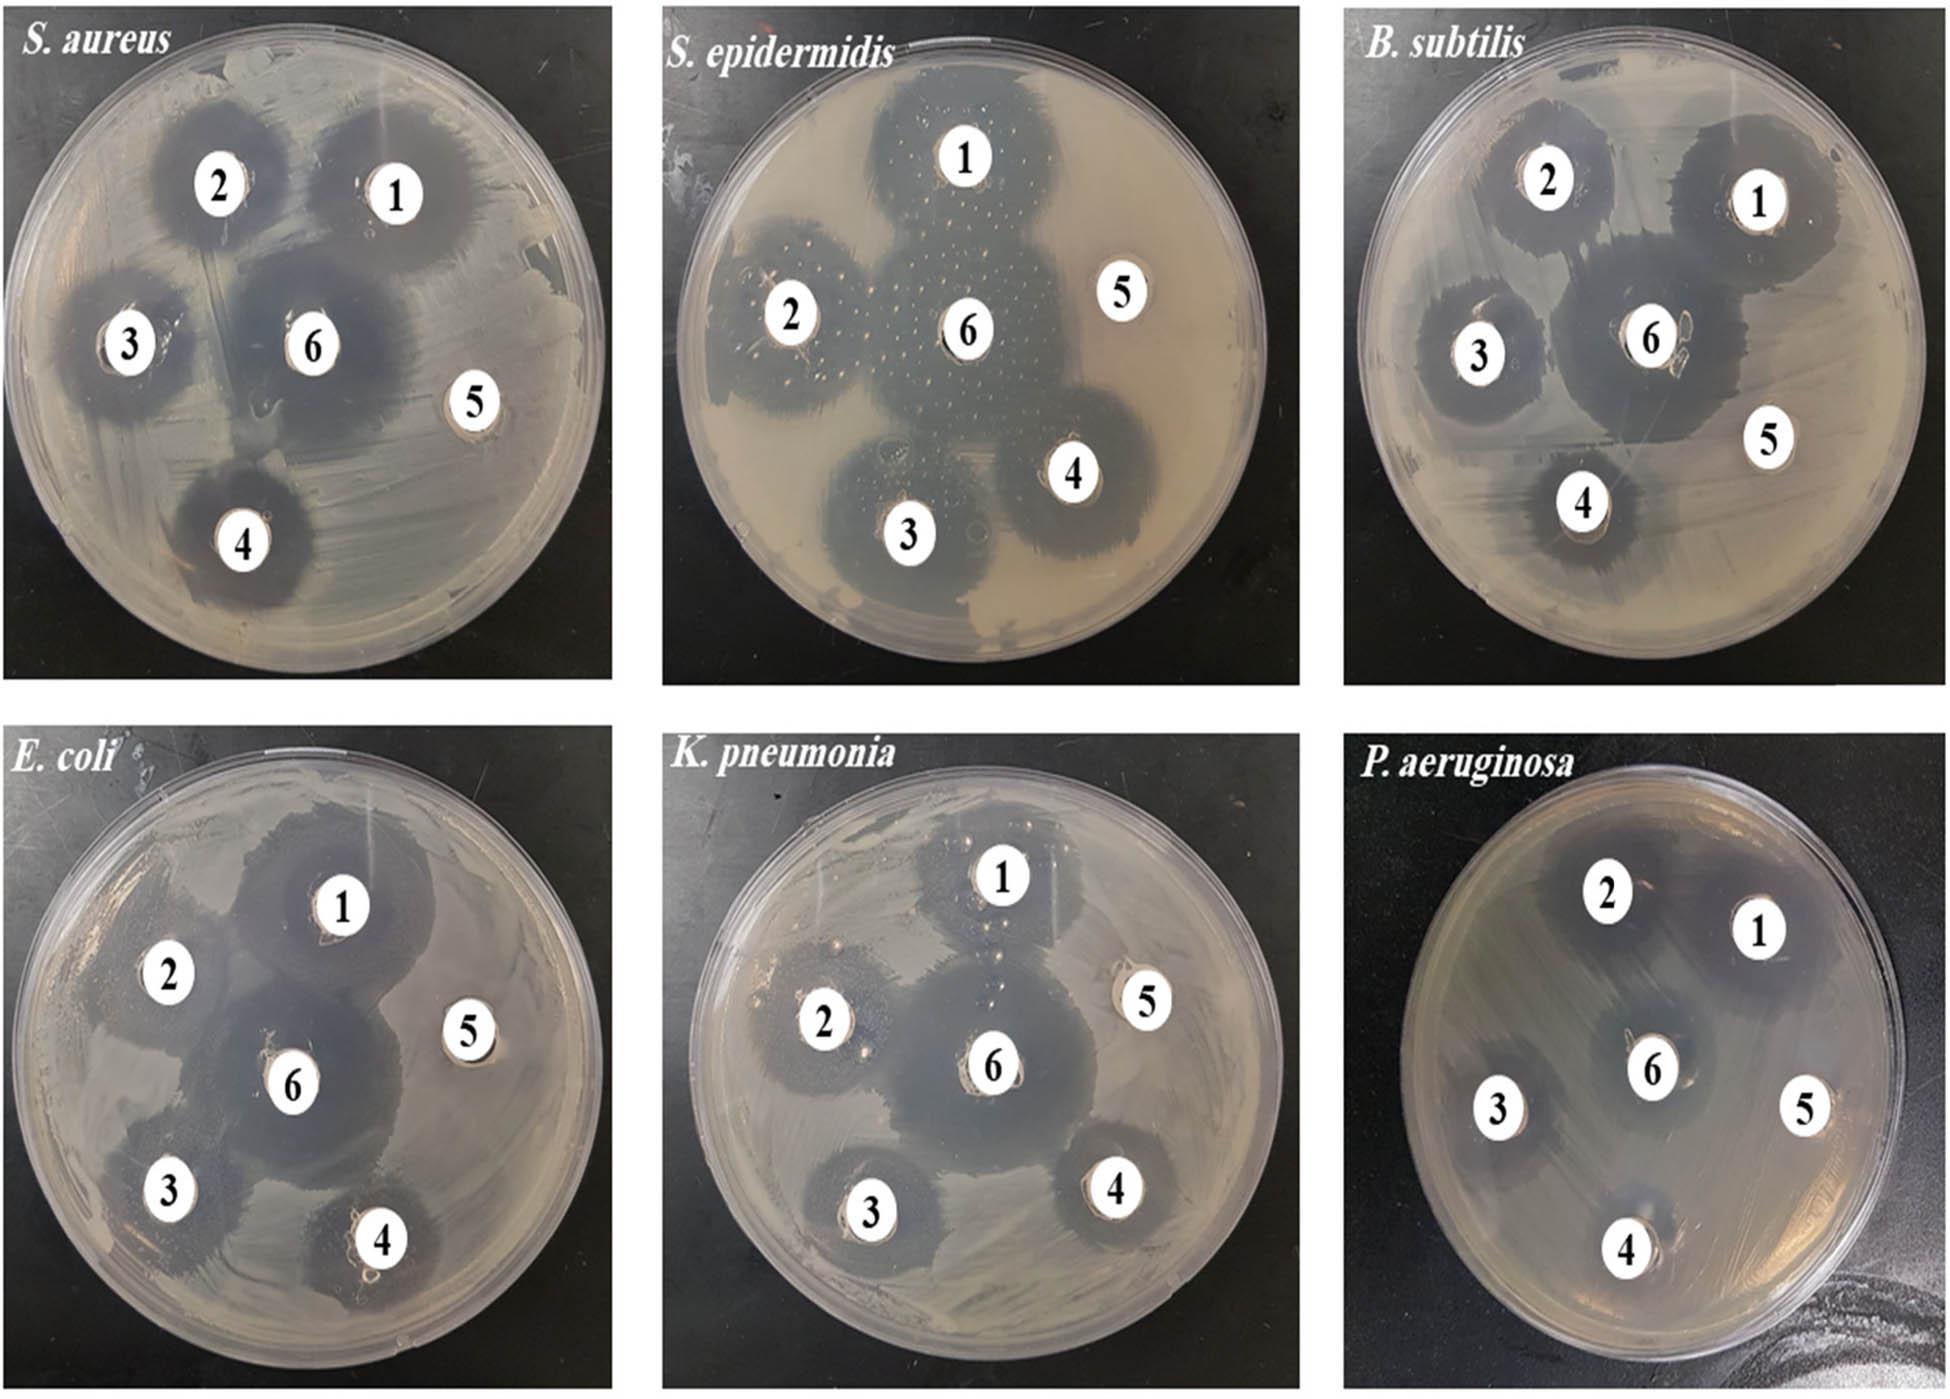
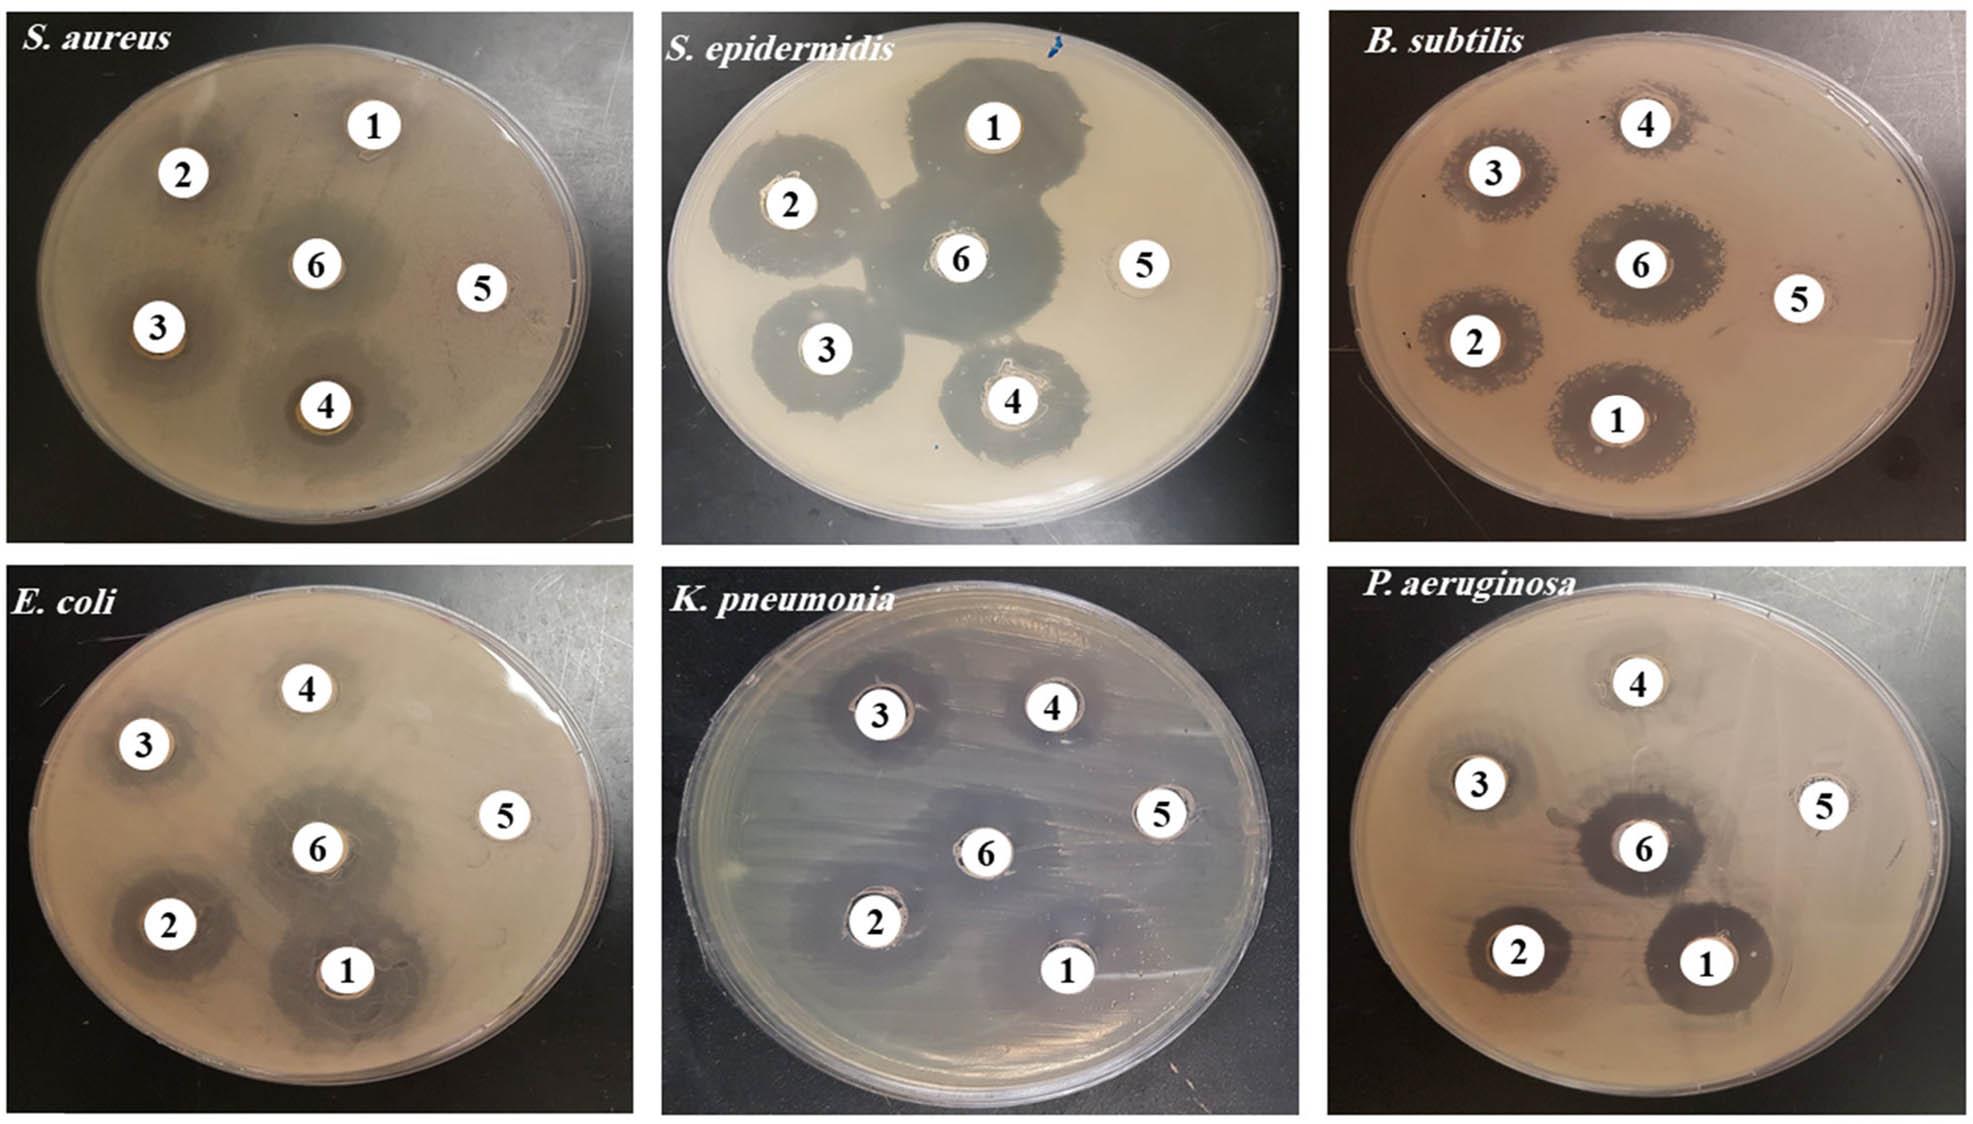

Globally, cancer is the second leading cause of mortality after cardiovascular diseases. Cancer-associated behaviors, such as smoking, inactivity, unhealthy eating habits, exposure to environmental chemicals and radiation, and the high cost of medical care and treatment, are the primary reasons for this. Cancer is a group of diseases that can affect any part of the body and is characterized by a rapid division of abnormal cells to surpass the normal limits of cell division. Worldwide, the most common types of cancer significantly vary, especially between developed and developing countries [1]. The rising prevalence of liver cancer has made it a major concern for global health. Approximately 905,700 individuals were diagnosed with liver cancer in 2020, leading to 830,200 deaths worldwide In Saudi Arabia, between the years 2014 and 2020, a total of 3,066 liver cancer cases were reported among Saudi nationals [2]. Breast cancer remains the most prevalent cause of fatalities among women all over the world. By 2020, it had overtaken lung and prostate cancers to become the most commonly diagnosed cancer type. The global incidence of breast cancer is increasing, and it has been estimated that the number of cases could reach 364,000 by 2040 [3]. The derived compounds from medicinal plants provide a wide range of chemical molecules that deserve to be investigated for development of modern medical treatments [4,5,6]. Over the past few decades, numerous compounds derived from the natural plants, with different abilities to activate signalling transduction pathways, have been identified [7,8,9,10,11]. Plants are a significant source of pharmaceuticals, accounting for almost 25% of drugs prescribed globally. Moreover, globally, up to 200 plant species are recognized to have therapeutic impacts, emphasizing the rich diversity within the plant kingdom for medicinal applications [12]. Senna is a member of the Fabaceae family that is found all over the globe, but it is mostly predominant in tropical and subtropical areas of Africa, Asia, Europe, and Latin America [13]. There are over 250–300 species of Senna recognized all over the world. The roots, stems, leaves, and flowers of these species are rich in a variety of phytochemicals. The in vitro, in vivo, and clinical trials on the prepared extracts from Senna plants exhibited a range of advantageous benefits via their potent antioxidant and antibacterial properties [14]. A wide range of biological and pharmacological characteristics have been determined for the aerial and underground (root, bark, stem, leaf, seed, and fruit) portions, with exploration of various Senna spp. throughout the last 10 years [13]. Senna flowers have an interesting structural specialty that encompasses many flower asymmetry patterns and exceptional androecium variation [15]. S. italica leaves are rich in phenolics, quinone derivatives, and flavonoids, which have anti-inflammatory, antioxidant, and protective properties, with 5,000 mg/kg of body weight dosage of S. italica leaves is nontoxic [16].
Recent pharmacological research has validated the efficiency of crude extracts, fractions, or isolated metabolites derived from Senna spp., which exhibit a range of beneficial properties, including antimalarial, antidiabetic, antimicrobial, antioxidative, anti-inflammatory, and anticancer effects [13,17,18]. The methanolic leaf extract of S. alata demonstrated a growth inhibitory effect on the HepG2 liver cancer cell line, with IC50 value of 22.46 μg/mL [19]. An antiproliferative effect was observed in the Ethyl Acetate Extract of Senna alata (L) Roxb against Michigan Cancer Foundation-7 (MCF-7) breast cancer cells, with IC50 value of 5.90 µg/mL [20]. Recently, a new anthraquinone with anticancer potential against melanoma and leukemia cells was found in the barks of S. velutina roots. The anthraquinone 2′-OH-Torosaol I demonstrated enhanced selectivity for cancer cells and facilitated cell death by apoptosis through boosting caspase-3 activity and decreasing the mitochondrial membrane potential. It was also effective against cancer cell migration [21]. Recently, the produced silver nanoparticles using aqueous extract from the leaves of S. alexandrina, which grows naturally in Medina, Saudi Arabia, demonstrated significant biological activity against multidrug-resistant pathogens (MDRPs) like Escherichia coli, Acinetobacter baumanii/haemolyticus, Staphylococcus epidermidis, and Methicillin-resistant Staphylococcus aureus (MRSA) [22]. S. alata leaves showed the strongest antibacterial activity against the MDRPs, Vibrio cholerae, and Shigella flexneri, with minimum inhibitory concentrations (MIC) ranging from 4 to 128 μg/mL [23]. S. italica revealed antibacterial activity against both Gram-positive and Gram-negative bacteria, with MIC values of 0.16, 0.078, 0.16, and 0.078 mg/mL for Pseudomonas aeruginosa, Enterococcus faecalis, E. coli, and S. aureus, respectively [24]. Notably, the biological features of S. italica and S. velutina have been only revealed through a small number of preliminary studies. The S. velutina leaf extracts exhibited antioxidant activity and showed cytotoxic effects against Jurkat and K562 leukemic cell lines [25]. Since the rich and novel chemical composition of plant-extracts is revealed by using the Gas chromatography-mass spectrometry (GC-MS) technology and due to the growing interest in plant-based natural products in healthcare, and presence of significant research gap on studying the antimicrobial, antioxidant, and anticancer capabilities of seed extracts we aim to comprehensively investigate the chemical profiling, antioxidant capacity, antimicrobial activity, and anticancer properties of S. italica seeds methanol S. italica seed extract (MSISE) and S. velutina seeds (MSVSE) methanol extracts.
The seeds of S. velutina and S. italica were purchased at a local market in Riyadh, Saudi Arabia. First, they were thoroughly cleaned under running water to remove any surface contaminants and then left to cure dry at room temperature (25°C) for an additional 10 days. Before it was used in this work, the material was crushed into a powder using a coarse grinder (cat. Number (36AIZPK4262B1Z2), Horizon.). S. velutina and S. italica seeds were extracted using methanol of a high-performance liquid chromatography (HPLC) grade, as described in the study by Elsharkawy et al. [26]. A total of 50 mg seed powders were dissolved in 500 mL of methanol in water at (80:20, v/v); thus, the chemical constituents could be extracted by the solvents [27]. The mixture was incubated overnight on a rotary shaker/incubator (Yih-Der, LE-539, Taiwan) 100 rpm at room temperature (25°C). The contaminants or solid residues from the extracts were removed from the extract by using Whatman No. 1 filter paper. The purified mixtures were centrifuged for 20 min at 4,500 rpm and 4°C. The supernatant was then collected, and the solvent was evaporated by using a rotary evaporator at 30°C (cat. Number (05-000-461), Thermo Fisher Scientific Inc.) [28]. Finally, the dried extract was kept for further use in a refrigerator at 4°C. The yield % of extract was calculated using the following formula: Yield (%) = Weights of solvent free extract (g) × 100/dried extract weight [29].
The bioactive components were identified by using a GC-MS system connected to an Agilent 5977A MSD system with DB5-MS column (30 m length × 0.25 mm internal diameter and 0.25 μm phase thickness) from Agilent Technologies (Santa Clara, CA, USA) [30]. The intended temperature ranges were 40°C for 3 min, 280°C for 5 min, 290°C for 1 min, and a continuous 7.5°C each minute. The data were obtained using the GC-MS in the electron impact ionization mode and at 70 eV ionization voltage. Injector and detector temperatures were adjusted to 200 and 300°C, respectively. A consistent flow rate of 1 mL/min for the carrier gas (helium) and 20–500 amu quantity scanning range were specified by the MS. The utilized search libraries were Willey and the Mass Spectral Database of the National Institute of Standards and Technology (NIST). The parts with a matching factor of more than 90% were detected by comparing the components with those located in the computer libraries (Willey and NIST) that were linked to the GC-MS apparatus.
The TPC was determined by Folin–Ciocalteu method as described in the study by Wolfe and Liu [31]. A mixture of 0.1 mL of plant extract (1 mg/mL) and 3 mL of distilled water, 0.5 mL of Folin-Ciocalteu reagent and 2 mL of 20% NaHCO3 were added. After thoroughly mixing, the mixture was incubated at 45°C for 20 min. The samples were measured at 725 nm using a spectrophotometer (U2001 UV-vis spectrophotometer, Hitachi, Japan). The TPC was then calculated using the equation (y = 0.007x + 0.186, where co-efficient (R 2) = 0.991 for the MSISE and y = 0.002x + 0.0265, and R 2 = 0.997 for MSVSE, derived from established standard curve with the gallic acid equivalent (GAE) and the results were presented as mg GAE per mg of extract.
The TFC was ascertained utilizing aluminum chloride (AlCl3), as explored in reference [32]. In summary, 500 µL of each extract was combined with 1 mL of AlCl3 that had been dissolved in ethanol. Subsequently, 3 mL of sodium acetate solution (50 g/L) was incorporated into the mixture. After that, two drops of acetic acid were introduced. The produced solution was incubated for 30 min in a dark environment at a temperature of 23°C. The optical density (OD) was measured at a wavelength of 415 nm employing a spectrophotometer (U2001 UV-vis spectrophotometer, Hitachi, Japan). A standard curve derived from the quercetin equivalent (QAE) standard was used to compute the TPC. The standard curve equation for the MSISE was (y = 0.0014x + 0.107 with R 2 = 0.935), and for MSVSE was (y = 0.0017x + 0.0497, R 2 = 0.993). The readouts were shown as mg QAE/g of extract.
Using the previously published methodology [33]. We assessed the ability of MSISE and MSVSE to react with DPPH radicals using the DPPH radicals scavenging test. A combination of 200 μL methanol solutions of Senna extracts at concentrations of 100, 200, 400, and 800 μg/mL and DPPH solution (2 mL, 0.08 mM) were prepared. Subsequently, a working standard of the ascorbic acid (200 μL, 100–800 μg/mL) was involved. The reaction mixture was then left in total darkness for 30 min. A U2001 UV-vis spectrophotometer (U2001 UV–vis Spectrophotometer, Hitachi, Japan) was used to measure the absorbance at 517 nm. The IC50 values were obtained by calculating the fraction of DPPH scavenging activity.
The ABTS radicals scavenging assay was conducted utilizing the outlined methodology in previous literature [34,35] to ascertain the extractive capacity of MSISE and MSVSE. The ABTS solution (192 mg in 50 mL of distilled water) was mixed with 140 mM K2S2O8 solution. The combination was stored in the dark at room temperature (25°C) for 12 h. The OD of the prepared ABTS solution in methanol was adjusted from 0.02 to 0.70. The ABTS solution was supplemented with each concentration at 50 μL intervals and the absorbance was measured at 734 nm after 6 min incubation in the dark at room temperature. Both ascorbic acid and butylated hydroxytoluene were used as positive controls. The readouts of ABTS% and IC50 were presented.
In this study, the cytotoxicity properties of MSISE and MSVSE were in vitro examined using human hepatoma HepG2 (ATCC HB-8065) and breast cancer MCF-7 (ATCC HTB-22) cell lines [34,35]. The cells were grown in Dulbecco’s Modified Eagle Medium (DMEM) supplemented with 1% penicillin-streptomycin and fetal calf serum. The cells were allowed to grow at 37°C in a humidified atmosphere with 5% CO2. Cell viability was determined using a 3-(4,5-dimethylthiazol-2-yl)-2,5-diphenyl-2H-tetrazolium bromide (MTT) test. The principle of the MTT assay is that the yellowish MTT is reduced by mitochondria to create purple formazan granules [36]. The wells of a 96-well microplate were inoculated with 100 µL of cell suspension in DMEM. A fully formed monolayer sheet was produced by incubating the microplate for 24 h at 37°C, 95% humidity, and 5% CO2. In the growing medium, serial dilutions of the prepared extract solutions were solubilized in 0.1% dimethyl sulfoxide (DMSO) to create different concentrations ranging from 50 to 400 µg/mL. After treatment, the cells were cultured for 24 h at 37°C with 5% CO2. A positive control of 50 µg/mL cisplatin was used. The MSISE and MSVSE were not added to the culture of negative control cells. After incubation, 10 µL of the MTT solution was applied to each well. The cell culture plates were put in an operated shaker (MPS-1, Biosan, London, UK) at 150 rpm for 5 min to mix the constituents and then were incubated for 4 h. A metabolic byproduct of the MTT called formazan was resuspended in 100 µL of DMSO and shaken vigorously for 5 min at 150 rpm. The OD at 570 nm was measured with ELX-808 microplate reader (BioTek Laboratories, LL, Shoreline, W.A, USA) and the applied reference wavelength was 620 nm. The cell viability (%) was determined by calculating the mean value of three independent experiments and after accounting for the mean value during data processing, the IC50 value was determined [37].
The antibacterial activity of MSISE and MSVSE was analyzed by the agar disc diffusion method as previously described [38]. Three Gram-positive (Staphylococcus aureus, MTCC-29213; Staphylococcus epidermidis, MTCC-12228; Bacillus subtilis, MTCC-10400) and three Gram-negative (Escherichia coli, ATCC-25922; P. aeruginosa, MTCC-27853; Klebsiella pneumonia, MTCC-13883) microorganisms were included. Subculture from the six bacterial spp. was prepared in 100 µL at 1.0 × 107 CFU/mL on Muller Hinton Agar (MHA). To create wells, holes with 5 mm diameters were punched at equal intervals using a sterilized corkborer. Next different concentrations of MSISE and MSVSE (100, 200, 400, and 800 µg/mL; 100 µL/well) were added to the wells. The positive control was chloramphenicol (25 µg/mL), while the negative control was Muller Hinton Broth (MHB) with 0.1% DMSO. The Petri dishes were incubated for 24 h at 37°C to promote microbial growth and assess the zone of inhibition around each well.
The MIC and MBC were measured using the microdilution method as indicated in the study by Basri and Sandra [39], where the 2,3,5-triphenyl tetrazolium chloride (TTC) with some changes was utilized. Initially, a primary culture from pathogenic bacteria was created at a concentration of 5 × 106 CFU/mL. Next 1.95–1,000 µg/mL of seed extracts was diluted with MHB and then100 µL of each dilution was applied to the wells of a 96-well plate, and bacteria were then added. The plate was incubated for 24 h at 37°C. After adding 20 µL (2 mg/mL) of TTC to each well, the growth of microorganisms was observed by observing the formation of a crimson color. According to its definition, the MIC is the concentration at which there is no discernible color change. Therefore, 100 μL from contents of each well that did not change color were cultivated on MHA and incubated at 37°C for 24 h and the smallest dilution that stopped growth was MBC [40].
GraphPad PRISM (version 5.0, La Jolla, CA, USA) software was used to analyze the obtained results. The mean value ± standard deviation (SD) of three independent experiments in triplicates was presented. The Student’s unpaired t-test was used to compare the mean values of two independent groups. For non-Gaussian variables, the Mann-Whitney U test was used to compare the groups. Differences were considered significant when the P-value was <0.05.
The yield of MSISE and MSVSE extracts were 38.14% and 3.487%, respectively, based on the applied operating mode and the dry matter weight computation (w/w).
The bioactive components of the MSISE and MSVSE recorded a total of 12 peaks, which were determined by comparing their peak retention time, peak area (%), molecular formula, and molecular weight with those of the identified compounds included in the NIST library. The predominant constituent in the MSISE was the n-hexadecanoic acid accounted for 32.48% from the total. The next constituents were 9,12,15-octadecatrienoic acid, (Z,Z,Z) (18.63%), 7,10,13-hexadecatrienoic acid, methyl ester (9.30%), and 1-Hexadecen-3-ol, 3,5,11,15-tetramethyl (9.29%) as presented in both Table 1 and Figure 1. However, the 2-Methoxystypandrone was the primary compound in the MSVSE and accounted for 30.21% from the total. The following compounds were 2-Pentadecanone, 6,10,14-trimethyl (11.68%), and Luteolin (9.13%) (Table 2 and Figure 2).
GC-MS compounds in MSISE
| Peak | Retention time (min) | Area (Ab*s) | Area% | Hit name | Molecular formula | Molecular weight (amu) |
|---|---|---|---|---|---|---|
| 1 | 18.719 | 633,215 | 6.04 | Bicyclo[3.1.1]heptane, 2,6,6-trimethyl-, [1R-(1.alpha., 2.beta., 5.alpha.)]- | C10H18 | 138.141 |
| 2 | 18.825 | 134,340 | 1.28 | 2-Pentadecanone, 6,10,14-trimethyl- | C18H36O | 268.277 |
| 3 | 18.994 | 117,647 | 1.12 | 3-Eicosyne | C20H38 | 278.297 |
| 4 | 19.188 | 246,133 | 2.34 | 3,7,11,15-Tetramethyl-2-hexadecen-1-ol | C20H40O | 296.308 |
| 5 | 19.67 | 707,885 | 6.75 | Hexadecanoic acid, methyl ester | C17H34O2 | 270.256 |
| 6 | 20.126 | 3,402,460 | 32.48 | n-Hexadecanoic acid | C16H32O2 | 256.24 |
| 7 | 21.421 | 974,978 | 9.30 | 7,10,13-Hexadecatrienoic acid, methyl ester | C17H28O2 | 264.209 |
| 8 | 21.527 | 973,232 | 9.29 | 1-Hexadecen-3-ol, 3,5,11,15-tetramethyl- | C20H40O | 296.308 |
| 9 | 21.878 | 1,952,413 | 18.63 | 9,12,15-Octadecatrienoic acid, (Z,Z,Z)- | C18H30O2 | 278.225 |
| 10 | 23.723 | 495,935 | 4.73 | Cyclododecyne | C12H20 | 164.157 |
| 11 | 25.049 | 511,866 | 4.88 | Hexadecanoic acid, 2-hydroxy-1-(hydroxymethyl)ethyl ester | C19H38O4 | 330.277 |
| 12 | 27.27 | 325,433 | 3.10 | Squalene | C30H50 | 410.391 |

The GC-MS chromatograms of MSISE. All spectral peaks correlate with the identified chemicals, with a major peak indicating the primary constituent of the extract.
GC-MS compounds in MSVSE
| Peak | Retention time (min) | Area (Ab*s) | Area% | Hit name | Molecular formula | Molecular weight (amu) |
|---|---|---|---|---|---|---|
| 1 | 7.766 | 631,469 | 8.11 | Cyclododecyne | C12H20 | 164.157 |
| 2 | 11.112 | 397,355 | 5.11 | Benzofuran, 2,3-dihydro- | C8H8O | 120.058 |
| 3 | 15.147 | 489,738 | 6.29 |
| C6H12O5 | 164.068 |
| 4 | 19.119 | 271,125 | 3.48 | ‘Catechin | C15H14O6 | 194.08 |
| 5 | 19.67 | 710,840 | 9.13 | Luteolin | C15H10O6 | 270.256 |
| 6 | 20.014 | 368,308 | 4.73 | n-Hexadecanoic acid | C16H32O2 | 256.24 |
| 7 | 21.409 | 908,989 | 11.68 | 2-Pentadecanone, 6,10,14-trimethyl- | C18H36O | 268.277 |
| 8 | 21.74 | 2,350,092 | 30.21 | 2-Methoxystypandrone | C14H12O5 | 260.24 |
| 9 | 22.691 | 315,893 | 4.06 | 9,12-Octadecadienoic acid (Z,Z)- | C18H32O2 | 280.24 |
| 10 | 24.217 | 139,704 | 1.79 | Kaempferol 3-O-rutinoside | C27H30O15 | 266.225 |
| 11 | 24.311 | 259,712 | 3.33 | cis,cis-7,10,-Hexadecadienal | C16H28O | 236.214 |
| 12 | 25.093 | 622,846 | 8.01 | Hexadecanoic acid, 2-hydroxy-1-(hydroxymethyl)ethyl ester | C19H38O4 | 330.277 |
| 13 | 26.231 | 311,334 | 4.01 | 9-Octadecenoic acid (Z)-, 2-hydroxyethyl ester | C20H38O3 | 326.282 |

The GC-MS chromatograms of MSVSE. A prominent peak in the spectrum indicates the major component of the extract, and every peak reflects a recognized chemical.
The results of the TPC for the MSISE extract was higher (146.34 mg GAE/g) than that for the MSVSE (138.13 mg GAE/g) extract. The TFC for the MSISE extract was 94 mg QE/g and was 69 mg QE/g for the MSVSE extract.
The potent antioxidant activity of MSISE and MSVSE was compared using the DPPH and ABTS radical scavenging test, with ascorbic acid serving as a positive control (Figure 3). The results of both DPPH and ABTS showed higher antioxidant activity at high doses of MSISE and MSVSE. Nevertheless, MSISE and MSVSE were significantly (P < 0.05) less effective in comparison to the positive control (IC50 = 28.11 μg/mL). The IC50 value (113.41 μg/mL) of the MSISE’s DPPH scavenger effect was shown to be much greater than that of the MSVSE (IC50 = 162.42 μg/mL). Additionally, the MSISE IC50 value (90.71 μg/mL) showed more antioxidant activity compared to the MSVSE IC50 value (176.11 μg/mL) against the ABTS free radical.

Antioxidant activity of MSISE and MSVSE. (a) DPPH reducing power and (b) ABTS (+) scavenging activity at various concentrations (100–800 μg/mL). An ascorbic acid (200 µg/mL) was used as a positive control. The mean value of three independent experiments is presented. The scavenging activity of MSISE and MSVSE was significantly lower (*) than the positive control at a significance level of P < 0.05. ˙ + = radical cation.
The anticancer effectiveness of MSISE and MSVSE was evaluated using the MTT test against MCF-7 and HepG2 cells. Our results demonstrated that MSISE and MSVSE decreased the viability of the MCF-7 and HepG2 cancer cells in a dose-dependent manner. After 100 μg/mL of MSISE and MSVSE, they were able to significantly (P < 0.05) inhibit cellular growth of MCF-7 and HepG2 lines as compared to the untreated control cells but less than the positive control (50 µg/mL of cisplatin). In examining both the MSISE showed higher cytotoxic impacts with (IC50 = 146.12 and 95.82 μg/mL against MCF-7 and HepG2 cells, respectively, than the MSVSE, the IC50 = 196.12 and 141.95 μg/mL, respectively (Figure 4a and b).

The effect of MSISE (a) and MSVSE (b) on MCF-7 and HepG2 cell viabilities using the MTT assay. Cells were treated with MSISE and MSVSE (0–800 μg/mL) for 24 h. Mean values ± SD of three independent experiments are shown. (* = P < 0.05 compared to non-treated cells [negative control]).
The antibacterial activity of MSISE and MSVSE was evaluated in comparison to the controls utilizing the disc diffusion method. The results revealed that both MSISE and MSVSE suppressed growth of the all-tested bacteria in a dose-dependent manner. The antibacterial activity of MSISE and MSVSE increased gradually as concentration increased; at 400 and 800 μg/mL, the inhibitory zone started to rise significantly (P < 0.05), although not as much as the positive control (25 µg/mL of chloramphenicol). The MSISE showed more antibacterial activity MIC = 7.81–31.25 μg/mL (Table 3 and Figure 5) than MSVSE (MIC = 15.62–62.5 μg/mL). Gram-positive bacteria were more vulnerable to MSISE, with MIC values ranging from 7.81 to 15.62 μg/mL, whereas Gram-negative bacteria were more resistant, with MIC values ranging from 15.62 to 31.25 μg/mL. However, the antibacterial efficacy of MSVSE against Gram-positive (MIC ranged from 15.62 to 31.25 μg/mL) and Gram-negative bacteria (MIC ranged from 31.25 to 62.5 μg/mL) indicated greater susceptibility of the Gram-positive bacteria to MSVSE (Figure 6; Table 4).
Inhibitory zone (mm), MIC, and MBC of MSISE
| Bacterium/dilution | Positive control | 1,000 μg/mL | 500 μg/mL | 250 μg/mL | 125 μg/mL | MIC (μg/mL) | MBC (μg/mL) |
|---|---|---|---|---|---|---|---|
| S. aureus | 31 ± 0.00 | 21 ± 0.00* | 18 ± 0.00* | 16 ± 0.00* | 14 ± 0.00* | 15.62 ± 0.00 | 31.25 ± 0.00 |
| S. epidermidis | 33 ± 0.00 | 24 ± 0.00* | 20 ± 0.00* | 17 ± 0.00* | 14 ± 0.00* | 7.81 ± 0.00 | 15.62 ± 0.00 |
| B. subtilis | 29 ± 0.00 | 22 ± 0.00* | 18 ± 0.00* | 11 ± 0.00* | 9 ± 0.00* | 15.62 ± 0.00 | 31.25 ± 0.00 |
| E. coli | 30 ± 0.00 | 23 ± 0.00* | 18 ± 0.00* | 10 ± 0.00* | 8 ± 0.00* | 31.25 ± 0.00 | 62.5 ± 0.00 |
| K. pneumoniae | 29 ± 0.00 | 15 ± 0.00* | 11 ± 0.00* | 9 ± 0.00* | 7 ± 10.00 | 31.25 ± 0.00 | 62.5 ± 0.00 |
| P. aeruginosa | 18 ± 0.00 | 22 ± 0.00* | 19 ± 0.00* | 15 ± 0.00* | 10 ± 0.00* | 15.62 ± 0.00 | 31.25 ± 0.00 |
* in the same column is significantly different from positive control according to Student’s t-test with P < 0.05 values considered significant.
Antibiogram demonstrating the antibacterial activity of MSISE against the studied Gram-positive and Gram-negative bacterial strains. (1) 1,000 μg/mL; (2) 500 μg/mL; (3) 250 μg/mL; (4) 125 μg/mL; (5) negative control; (6) chloramphenicol (25 µg/ml), positive control.
Antibiogram demonstrating the antibacterial activity of MSVSE against the studied Gram-positive and Gram-negative bacterial strains. (1) 1,000 μg/mL; (2) 500 μg/mL; (3) 250 μg/mL; (4) 125 μg/mL; (5) negative control; (6) chloramphenicol (25 µg/ml), positive control.
Inhibitory zone (mm), MIC, and MBC of MSVSE
| Bacterium/dilution | Positive control | 1,000 μg/mL | 500 μg/mL | 250 μg/mL | 125 μg/mL | MIC (μg/mL) | MBC (μg/mL) |
|---|---|---|---|---|---|---|---|
| S. aureus | 31 ± 0.00 | 20 ± 0.00* | 18 ± 0.00* | 14 ± 0.00* | 13 ± 0.00* | 31.25 ± 0.00 | 62.5 ± 0.00 |
| S. epidermidis | 33 ± 0.00 | 21 ± 0.00* | 17 ± 0.00* | 12 ± 0.00* | 10 ± 0.00* | 15.62 ± 0.00 | 31.25 ± 0.00 |
| B. subtilis | 29 ± 0.00 | 20 ± 0.00* | 18 ± 0.00* | 11 ± 0.00* | 9 ± 0.00* | 15.62 ± 0.00 | 31.25 ± 0.00 |
| E. coli | 30 ± 0.00 | 24 ± 0.00* | 18 ± 0.00* | 12 ± 0.00* | 10 ± 0.00* | 31.25 ± 0.00 | 62.5 ± 0.00 |
| K. pneumoniae | 29 ± 0.00 | 23 ± 0.00* | 20 ± 0.00* | 14 ± 0.00* | 11 ± 10.00* | 31.25 ± 0.00 | 62.5 ± 0.00 |
| P. aeruginosa | 18 ± 0.00 | 17 ± 0.00 | 11 ± 0.00* | 9 ± 0.00* | 8 ± 0.00* | 62.5 ± 0.00 | 125 ± 0.00 |
* in the same column is significantly different from positive control according to Student’s t-test with P < 0.05 values considered significant.
Seed extracts have proven numerous health benefits. Several studies have shown that seed extracts can protect human health. Research on seed extracts has been extensive and has included nigella, sunflower, chia, fenugreek, pumpkin, and grape seeds [41,42]. The present work is conducted on MSVSE and MSISE to investigate their bioactive components and biological activities.
The observed differential yield between MSVSE and MSISE suggest that factors like the used plant part, drying method, solvent concentration, extraction duration, and other processing parameters can be the reason behind the differential yield of the methanolic extraction of MSISE and MSVSE. Yield is often stated as a percentage of the plant’s dry weight, which contains a wide range of bioactive chemicals, including phenolic acids, flavonoids, and sesquiterpene lactones [43]. In the present study, the applied Folin–Ciocalteu method on the MSISE demonstrated a high concentration of TPC (146.34 mg GAE/g), which is higher than the MSVSE extract (138.13 mg GAE/g). The results go in line with earlier research where the leaves of S. italica showed a wide range of important secondary metabolites, such as catechic tannins, anthocyanins, leucoanthocyanins, flavonoids, alkaloids, anthraquinones, and reduction compounds [44]. The higher TPC content indicates presence of substantial amounts of phenolic acids in the methanolic extract, which are known with their antioxidant properties [45]. Notably, the identified TFC was lower than the TPC. Flavonoids like quercetin and kaempferol are well known for their anti-inflammatory, antimicrobial, and anticancer properties [46]. Although flavonoids were less common than phenolics in MSISE and MSVSE, they contribute to the extract’s increased bioactivity.
Antibacterial and anti-inflammatory properties of plant extracts are among the numerous biological actions that can be explained by the balance between phenolic and flavonoid content [47]. The higher TFC implies that phenolic acids, which include caffeic acid, 5-hydroxymethylfurfural, and chlorogenic acid, are more important for the root’s bioactivity than flavonoids [48]. This has been reported in other studies where the S. italica extraction using different solvent, showed a higher TPC than TFC [14,16]. Additionally, the phenolic and flavonoid contents of a plant extract are significantly correlated with its antioxidant activity. Such good association indicates that the results appropriately reflect the phenolic and flavonoid content of the extract and validates the reliability of the colorimetric techniques used [49]. Overall, the high TPC of MSVSE and MSISE suggests that these substances may be effective sources of antioxidants, which might help with their medicinal use in the treatment of oxidative stress and related diseases. The root extract’s many benefits are highlighted by the high flavonoid concentration, which also strengthens its antibacterial and anti-inflammatory properties. The GC-MS analysis of the MSISE indicated that n-hexadecanoic acid, 9,12,15-octadecatrienoic acid, and 7,10,13-hexadecatrienoic acid were the most prevalent compounds. In contrast, the primary components identified in the MSVSE were 2-methoxystypandrone, 2-pentadecanone, 6,10,14-trimethyl, and luteolin. N-hexadecanoic acid is a significant bioactive ingredient that may improve MSISE’s overall therapeutic potential due to its antibacterial, anti-inflammatory, and antioxidant properties [50]. Similar findings have been reported by other studies where n-hexadecanoic acid was linked to potential health benefits including anti-inflammatory, antibacterial, and antioxidant activities, and was defined to be a significant component of several plant extracts [50,51,52]. The 2-methoxystypandrone affects the development of oxidative stress as well as the proliferation of Jurkat cell lines. Our results explored that 2-methoxystypandrone significantly depolarizes the mitochondria by increasing reactive oxygen species (ROS) generation and decreasing the expression of antioxidant enzymes on mRNA [53]. 9,12,15-Octadecatrienoic acid was extracted as an anti-inflammatory chemical from the methanol extract of Ehretia dicksonii and demonstrated inhibitory efficacy toward soybean lipoxygenase [54]. The natural flavonoid luteolin is found in large quantities in fruits, vegetables, and herbs. Research has demonstrated that luteolin has antioxidant, anti-cancer, and anti-apoptotic properties [55,56]. Its capacity to inhibit angiogenesis, induce apoptosis, prevent carcinogenesis in animal models, reduce tumor growth in vivo, and sensitize tumor cells to the cytotoxic effects of some anticancer drugs suggests that luteolin may have chemopreventive and chemotherapeutic potential. The biological activities of luteolin may be mediated by the inhibition of PI3K, STAT3, IGF1R, and HER2, as well as the stabilization of p53 and the inhibition of ROS activities [55].
DPPH and ABTS are the most widely used methods for evaluating antioxidant capacity due to their simplicity, speed, sensitivity, and utilization of stable radicals [57]. According to these results, MSISE and MSVSE have a modest level of antioxidant activity. This activity is not as high as that of ascorbic acid, but it is still significantly higher than that of free radical scavenging. This indicates that the low hydrogen-donating capacity of MSISE and MSVSE is comparable to that of ascorbic acid, the reference chemical. The elevated phenolic component levels may be the cause of the moderate activity. Phenolics are well known for their exceptional ability to scavenge free radicals and donate electrons [49]. The observed disparity in activity between the DPPH and ABTS tests can be explained by pointing out the distinct mechanisms involved in radical scavenging. The ABTS assay is more sensitive to antioxidants that donate electrons, while the DPPH test refer to hydrogen-donating capacity [58]. The bioactive components found by GC-MS, such as 2-methoxystypandrone and n-hexadecanoic acid, which have been shown to have antioxidant characteristics, can also be linked to the modest antioxidant activity of MSISE and MSVSE. These components also contribute to the recorded free radical scavenging activity as demonstrated in other studies [59,60]. The chemical composition and antioxidant activity of S. velutina leaf ethanol extracts were investigated by Campos et al. (2016) using the DPPH technique. These findings suggest that S. velutina leaves have a greater antioxidant activity (3.5 times higher than BHT) but a lower antioxidant activity than ascorbic acid [25]. The inclusion of phenolic acids in the TPC assay adds to the moderate antioxidant activity, as these chemicals are known to be effective radical scavengers. In compliance with these findings, a recent study evidenced the anti-inflammatory, antioxidant, and protective qualities of flavonoids, quinone derivatives, and phenolics found in abundance in S. italica leaves [16].
The anticancer activity of MSISE and MSVSE against MCF-7 and HepG2 cells showed a dose-dependent reduction in viability. These data indicate that MSISE and MSVSE have considerable anticancer efficacy, especially when compared to the positive control, cisplatin (30 μg/mL). The lower IC₅₀ value indicated that MSISE and MSVSE were considerably more active against HepG2 cells than MCF-7 cells. This might be related to the variety of phytochemical components, particularly the presence of bioactive compounds. Due to their ability to stop angiogenesis, trigger apoptosis, and reduce the development of cancer cells, these substances are known to have anticancer properties [61]. A previous research reported that the cancer cell lines HepG2, Hela, PC3, and MCF-7 are similarly susceptible to the dose-dependent cytotoxicity of the S. italica methylene chloride and n-hexane extract, the methylene chloride showed a strong anticancer activity compared to n-hexane extracts [62]. The acetone extract of the roots of S. italica inhibited the proliferation and viability of Jurkat T cells by the arrest of the cell division cycle at one of the checkpoints (either G1/S or G2/M interphases) in the cell division cycle [24]. A new anthraquinone (2′-OH-Torosaol I) with anticancer potential against melanoma and leukemia cells was found in the barks of S. velutina roots in recent research, 2′-OH-Torosaol I observed that it greatly decreased the viability of B16F10-Nex2, SK-Mel-19, SK-Mel-28, and SK-Mel-103 cell lines but, did not affect the normal peripheral blood mononuclear cell viability. Reduction in mitochondrial membrane potential, elevation of ROS, and activation of caspase-3 were the mechanisms by which the chemical caused apoptosis via the intrinsic route. Furthermore, the inhibitors indicated that one of the primary routes of programmed cell death produced by 2′-OH-Torosaol I is caspase-dependent apoptosis death and showed the involvement of necroptosis and Ca2+ in the death process [21]. Accordingly, our study suggests potential use of MSISE and MSVSE as a natural anticancer drug.
On the other hand, the MSISE and MSVSE exhibited broad-spectrum antibacterial activity against both Gram-positive and Gram-negative bacteria as indicated by MIC, MBC, and disc diffusion techniques. Importantly, Gram-positive bacteria were shown to be more susceptible to both MSISE and MSVSE compared to Gram-negative bacteria. This could be due to targeting their cell walls. In contrast, Gram-negative bacteria have an outer membrane that functions as a barrier, making them more resistant to various antimicrobial treatments [63,64]. Gram-positive bacteria were more susceptible to plant-based extracts rich in flavonoids, phenolic acids, and sesquiterpene lactones. These substances may damage bacterial cell walls, obstruct important enzymes, or interfere with DNA synthesis to carry out their antibacterial activities [46,65]. Additionally, the antibacterial effect of MSISE and MSVSE may be facilitated by the presence of essential components such as n-hexadecanoic and 2-methoxystypandrone acid [60,66]. Different Senna species extracts were shown to have varying antibacterial activity [14]. The antibacterial activity of S. italica against Gram-positive and Gram-negative bacteria P. aeruginosa, E. faecalis, E. coli, and S. aureus was shown by Masoko et al. [24].
We accept the limits and inadequacies of the used approach in this research. Further investigation is necessary to confirm the newly discovered compounds. To compute the retention indices of the components, linear interpolation about the retention lengths of two typical n-alkane mixtures (C8–C20 and C21–C40) must be used. One drawback of the study is the dearth of in vivo research. The in vivo context presents a far more complex picture in terms of target organ delivery, effectiveness, and potential problems. In-vivo investigations should be prioritized in future research to ascertain the safety and efficacy of these compounds.
The present study offers novel insights on the therapeutic potential of MSISE and MSVSE, analyzing their bioactive contents and exploring their complex pharmacological activities. In contrast to the majority of previous research, this is the first study to compare MSISE with MSVSE in terms of chemical profile, antioxidant, anticancer, and antibacterial activity. The GC-MS analysis of MSVSE and MSISE showed 13 and 12 bioactive compounds, respectively, and some of them are unique. Overall, this study demonstrates the wide spectrum of uses for MSISE and MSVSE as antioxidant and anticancer medications. Further research is necessary to determine the mechanisms of action and potential therapeutic uses of these substances, both alone and in combination, in light of the observed bioactivities. In vivo, studies should be the main focus of future research to evaluate the efficacy and safety of these medications.